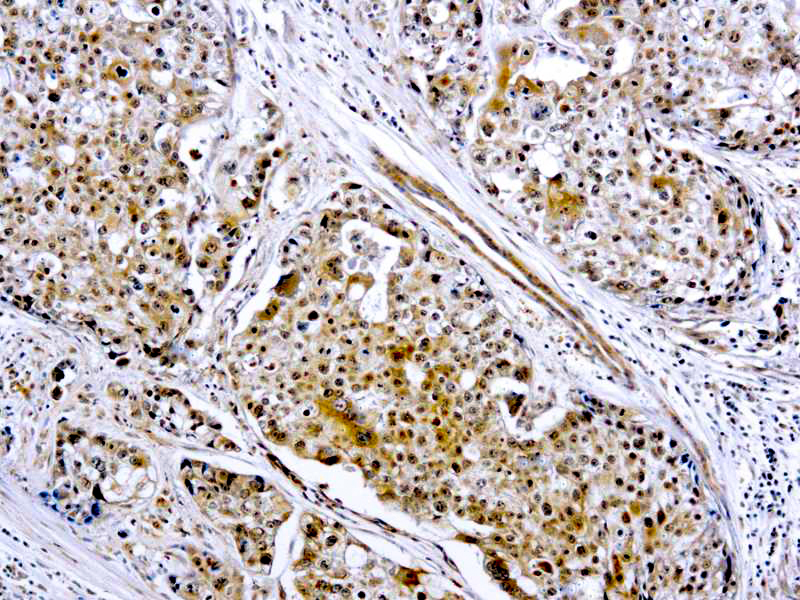

This antibody reacts with a 92 kDa pro form and 86 kDa active form of MMP9. MMPs are proteolytic enzymes capable of degrading connective tissue components. MMPs play a crucial role in tumor cell invasion and metastasis.
MMP-9
SKU: 5308
Categories: Primary Antibodies, IVD - Outside U.S. Market, RUO - For U.S. Market
Tags: M, Concentrated
Description
Additional information
| Clone | Rabbit |
|---|---|
| Immunogen | A synthetic peptide from the middle region of human MMP-9. |
| Species | Rabbit |
| Cellular Localization | Cytoplasmic |
| Positive Control Tissue | Breast carcinoma |
| Pretreatment | None |
| Incubation & Temperature | 30 min @ RT |
| Intended Use | IVD, RUO |
| Detection System | PolyVue Plus – Two Step Detection System or Montage PolyVue Plus Auto Detection System for Montage 360 System |
| Description/Type | Rabbit Polyclonal Antibody |
| Format | Purified immunoglobulin fraction ofrabbit antiserum against human MMP9 containing sodium azide as a preservative. |
DATASHEETS & SDS
DATASHEETS & SDS
| Download Datasheet |
| Download SDS Sheet – OSHA |
REFERENCES
REFERENCES
- Jackson et al. Intl J Biochem Cell Biol 29 (10): 1167, 1997.
- Paquet et al. Eur J Clin Invest 28 (7): 528, 1998.
Reviews (0)
Only logged in customers who have purchased this product may leave a review.

Reviews
There are no reviews yet.